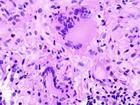
分枝桿菌

治療原則
1. 貫徹抗結核化學藥物治療(以下簡稱化療)的“十字方針”:
(1) 早期:應儘可能早發現和早治療。
(2) 聯合:聯合套用多種抗結核病藥物,提高殺菌力,防止產生耐藥性。
(3) 適量:劑量適當,減少不良反應和細菌耐藥性的產生。
(4) 規則:按照化療方案,按時、規範服藥。
(5) 全程:必須教育患者堅持完成全療程治療。
 分枝桿菌
分枝桿菌2. 化療方案的制訂與調整用藥的基本原則:
(1) 按照患者不同的病變類型選用國際和國內推薦的標準化療方案。
(2) 對獲得性耐藥患者的化療方案中,至少包含有2種或2種以上患者未曾用過或病原菌對之敏感的藥物。
(3) 切忌中途單一換藥或加藥,亦不可隨意延長或縮短療程。掌握好停藥或換藥的原則。
(4) 治療過程中偶爾出現一過性耐藥,無須改變正在執行的化療方案。
(5) 合併人類免疫缺陷病毒感染或愛滋病患者避免使用利福平。
3.痰結核菌陽性的肺結核病患者是治療的主要對象,痰菌陰性但病灶活動者亦應予以治療。
病原治療
 分枝桿菌
分枝桿菌1. 一般分為強化治療階段(強化期)和鞏固治療階段(鞏固期),標準短程化療(療程6~9個月)方案中強化階段以3~4種藥物聯合套用8~12周,鞏固階段以2~3種藥物聯合套用。
2. 用藥方式:(1)全程每日用藥;(2)強化期每日用藥,鞏固期間歇用藥;(3)全程間歇用藥。
3. 治療慢性傳染性肺結核、耐多藥結核病的可選藥物:對氨水楊酸、丙硫異煙胺、捲曲黴素、環絲氨酸、阿米卡星、氧氟沙星等氟喹諾酮類和克拉黴素、氯法齊明等。
4. 治療慢性傳染性肺結核、耐多藥結核病的療程:強化期至少3個月,鞏固期至少18個月。
分枝桿菌介紹
分枝桿菌
分枝桿菌 分枝桿菌由結核分枝桿菌複合群和非結核性分枝桿菌組成,目前已知的分枝桿菌種類已達到90種,其中包括致病菌,機會致病菌和非致病性分枝桿菌三類。在分枝桿菌屬當中,最重要的種類當屬結核分枝桿菌,它是結核的病原菌。結核病(TB)是目前世界上首要的感染性疾病,每年有800萬人感染結核,有200萬人死於結核病。鳥分枝桿菌是臨床最常見的非結核性分枝桿菌中的一種,尤其好發於AIDS患者。
資料顯示,隨著ADIS疾病的出現,醫源性免疫抑制的發生率增高,非結核分枝桿菌疾病發生率也在不斷增加,且所占感染比例有不斷上升的趨勢[4]。尤其當患者伴隨免疫缺陷狀態時,我們發現許多以前認為是非致病性的分枝桿菌現在表現為致病菌,尤其是一些罕見的分枝桿菌,隨之而來的是新的分枝桿菌種類的發現。結核與其他分枝桿菌疾病最主要的區別在於結核通過人與人之間傳播,而其他分枝桿菌存在於自然界。根據分枝桿菌種類的不同,相應抗生素的敏感性也有所不同。因此我們需要快速敏感的分子生物學技術快速診斷並提供有效治療方案。本綜述回顧了近十年來分枝桿菌分子生物學診斷技術的最新進展及其意義。
臨床標本中分枝桿菌的分子水平檢測
傳統診斷臨床標本的分枝桿菌感染是基於鏡下抗酸染色,進而特殊培養及生化實驗鑑定菌種,最後檢測藥物敏感性。抗酸染色只能鑑別屬與屬外的特徵,且只有在標本帶菌量在104~106/ml時才能看見。由於多數分枝桿菌生長緩慢,鑑別到屬的水平需要耗時4~8周,隨著分子生物學的發展,現在有了比傳統檢驗更可靠的菌種診斷和鑑定技術,診斷所需時間由數周減少到數天。
1.PCR:單純PCR技術最初僅限於對臨床痰標本中的結核分枝桿菌進行檢測,根據結核分枝桿菌特有的IS6110插入序列設計特異引物,最後根據擴增出的目的片段來判斷陽性結果[5]。Kwon等[6]進一步將PCR技術套用拓展到福馬林固定的病理蠟塊,針對病理表現為淋巴肉芽腫的病理組織標本,利用分枝桿菌通用引物(目的片段383bp)和結核分枝桿菌複合群特異引物(目的片段123bp)。在20例標本中有10例經通用引物擴增顯示陽性,7例兩組引物擴增結果均為陽性。對於那些臨床懷疑淋巴結核但塗片和培養陰性的患者提供了分枝桿菌感染的證據。PCR技術的套用無疑大大縮短了實驗周期,且操作簡便,但是單純通過擴增產物在凝膠板上的遷移判定擴增的陽性與否還是不夠可靠,實際上,即使片段長度的等同也不應認為擴增產物就是目的片段,而應在片段長度和序列同源性兩個方面同時得到確認。
2.PCR結合探針雜交:Kirschner等[7]以16SrRNA為靶基因設計分枝桿菌屬的通用引物:Primer264(5’-TGCACAGGCCACAAGGGA-3’)Primer285(5’-GAGTTTGATCCTTGGCTCAGGA-3’),可同時擴增非結核性分枝桿菌。在PCR的基礎上,利用一系列特異性探針與擴增產物雜交反應進行種間區分。該實驗中PCR的敏感性為84.5%,特異性為99.5%。值得一提的是Kirschner的研究中涉及到除了痰標本以外的各種組織標本的處理,如軟組織、骨髓、尿液及腦脊液等,但遺憾的是在培養陽性的標本中PCR出現可觀的假陰性結果。Kox等[8,9]在1995年以16SrRNA為靶基因設計分枝桿菌屬的通用引物擴增臨床標本,擴增產物與9種特異性探針斑點雜交,同時鑑定9種分枝桿菌。Stauffer等[10]介紹了多重PCR體系快速檢測分枝桿菌的實驗方法,在套用16SrRNA為靶基因設計分枝桿菌通用引物進行擴增的基礎上,結合套用結核桿菌特異性引物(IS6110)進行多重PCR反應,PCR產物再與13種特異探針進行反向斑點雜交。PrimerpMyc14bio(5’-GRGRTACTCGAGTGGCGAAC-3’)pMyc7bio(5’-GGCCGGCTACCCGTCGTC-3’)擴增16SrDNA序列。PrimerPt18(5’-gaaccgtgagggcatcgagg-3’)INS2bio(5’-GCGTAGGCGTCGGTGACAAA-3’)擴增結核桿菌IS6110序列。該研究的意義在於某些結核分枝桿菌缺乏IS6110序列時,也能被基於16SrRNA的通用引物擴增,從而降低了假陰性率的發生,該研究的局限性在於目前所知分枝桿菌的種特異性探針數量有限,只能同時檢測13種分枝桿菌,而且在海分枝桿菌和潰瘍分枝桿菌以及堪薩斯和胃分枝桿菌之間存在探針重疊,因而無法鑑別。
與痰培養比較,PCR加核酸雜交法的敏感性為91.9%/79.4%;特異性為99.8%/99.6%[10]。在塗片陰性的標本中敏感性更低。基於PCR的診斷技術存在兩個主要問題:假陽性反應,多因污染了原來擴增反應的DNA片段;假陰性反應,由於存在干預PCR反應的抑制劑等。目前用於防止假陽性反應的措施為以尿嘧啶-N-糖基化酶和dUTP代替dTTP加入反應體系。使用硫氰酸胍和硅藻可以有效去除PCR反應抑制劑[12,13]。
分離菌株的菌種鑑定
 分枝桿菌
分枝桿菌傳統的分枝桿菌菌種鑑定基於一系列生化學試驗和顯型反應。生化試驗的缺點是耗時長,步驟繁複,而且可能產生模稜兩可的結果,因此目前越來越傾向於使用分子手段做種間鑑定。
1.DNAProbe:對於臨床常見致病分枝桿菌,已有現成可以獲得的DNA探針,包括結核分枝桿菌複合群、鳥、胞內、堪薩斯、戈登等分枝桿菌。探針經吖啶酯標記,結果經螢光光度計測定,實驗周期僅2h,方法簡便易行。缺陷已如前述:不是所有分枝桿菌都有已知的特異探針,結核桿菌複合群的探針不能區分人型,牛型及BCG等。
2.PCR-直接測序法:這種方法的基本過程是,先PCR擴增一模板DNA,然後對擴增片段進行測序。測序後或人工解讀或使用數據分析軟體自動解讀。基於PCR的測序已成為分枝桿菌菌種鑑定的金標準,甚至有人將此技術用於直接檢測標本中的分枝桿菌,尤其對於傳統培養不能生長的菌種[14,15]。常用的靶基因有:16S-rRNA基因,是非常理想的基因分類靶基因有如下優點:①其分子結構具有高度保守的特性,只在某些位置有少量的核苷酸序列改變,而這些位置的改變有分枝桿菌屬或種特異性。②許多分枝桿菌的16S-rRNA基因序列已測定完成。③長度適中,基因在細胞內有多拷貝。針對該基因兩個高度可變區進行測序可以鑑定大部分分枝桿菌菌種,但不能區別結核桿菌複合群,堪薩斯與非致病性胃分枝桿菌在此兩個區域序列相同,在區分海及潰瘍分枝桿菌時需另外測定16S-rRNA基因的其他序列[16,17]。Kirschner等[16]於1993年就利用這一方法實現了對52種分枝桿菌的菌種鑑定。另外32-kDa蛋白[18],65-kDa熱休克蛋白[19]和16S-23SrRNA區間序列包含足夠的序列多樣性,可以區分所有臨床上重要的分枝桿菌,也可鑑別堪薩斯和胃分枝桿菌。
3.PCR-RFLP:PCR-RFLP法是先擴增某一基因片段,再用限制性內切酶酶切擴增片段,然後電泳分析酶切片段。Vaneechout等[20]用rRNA基因邊緣存在的保守區設計引物擴增出1500bp的DNA片段,用Cfol、MboI和RsaI酶切擴增片段,分析了99株18種分枝桿菌。Cfol和MboI的RFLP圖譜能鑑定亞洲分枝桿菌、鳥、龜、偶然、戈登、胞內、海、土地、蟾蜍、和結核分枝桿菌複合群。進一步用RsaI可鑑定堪薩斯和瘰癘分枝桿菌。熱休克蛋白基因保守性較強,存在於所有分枝桿菌,用PCR擴增hsp65的439bp,用BstEⅡ和HeaⅡ酶切消化分析34種分枝桿菌,顯示出不同分子量的帶譜圖譜[21]。
4.PCR-SSCP:PCR-SSCP技術是目前套用較為廣泛的一種鑑別不同DNA片段的分析技術,始於1989年其原理是通過PCR擴增出的DNA,經變性產生兩條互補的DNA單鏈,由於鹼基序列及空間構象的不同,在非變性聚丙烯醯胺凝膠中呈現不同的帶型。實驗周期3~4d。最開始這種辦法是用來檢測序列突變,包括單鹼基替代,SSCP法分析16SrRNA擴增片段最近被廣泛用於代替基因測序,鑑別細菌種類。有學者套用免疫螢光毛細電泳系統的SSCP分析技術鑑別分枝桿菌菌種,結果證明是可靠並有效的。具體步驟為選擇16SrRNA基因不同區域的四個片段擴增,套用螢光標記引物,隨後分析它們的SSCP模式。針對40株包括30種分枝桿菌進行檢測,SSCP分析模式被輸入一個軟體程式BioNumerics1.5,完成自動分析。結果在30種分枝桿菌中有26種表現了獨特的8峰值,除了堪薩斯/胃,戈登/asiaticum表現為相同的SSCP模式。
5.基因芯片技術:基因晶片技術是最近發展起來的能夠大規模檢測遺傳多樣性的新技術。這種技術的基礎是將核苷酸靶序列和大量結合在玻底片、矽片或塑膠片上的基礎探針雜交。Troesch等[21]已經將該技術套用於分枝桿菌的菌種鑑定和結核分枝桿菌的耐藥基因的檢測。並建立兩個資料庫,一個是用於分枝桿菌的菌種鑑定(相對於54個菌種的82個獨特的16SrRNA基因序列),另一個是檢測結核分枝桿菌的利福平耐藥基因的。27種70株分枝桿菌和15株結核分枝桿菌利福平耐藥株中,26種分枝桿菌和所有的耐利福平突變體得以正確的鑑定。
總之,目前分枝桿菌菌種鑑定的分子生物學方法很多,均能對部分分枝桿菌進行快速鑑定,每種方法各有利弊,尚無統一的標準化的方法。技術方法的不斷改進及分枝桿菌遺傳信息的進一步詳盡地了解,將使分子水平上的診斷及菌種鑑定技術得到進一步的完善,對於分枝桿菌疾病的防治有重要意義。
所屬分類
敗血症生物致病因子和生物源性疾病
